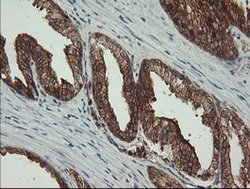
BRAF Mouse anti-Human, Clone: OTI1G8, lyophilized, TrueMAB 100 &mu;g | Buy Online | Origene Technologies | Fisher Scientific

missing translation for 'onlineSavingsMsg'
Learn More
Learn More
BRAF Mouse anti-Human, Clone: OTI1G8, lyophilized, TrueMAB™

Descripción
Reconstitute with PBS (pH 7.3) and recommend to perform another round of desalting process using Product No. 7KMWCO
B-raf belongs to the raf/mil family of serine/threonine protein kinases. This protein plays a role in regulating the MAP kinase/ERKs signaling pathway, which affects cell division, differentiation, and secretion. Mutations in the gene are associated with cardiofaciocutaneous syndrome, a disease characterized by heart defects, mental retardation and a distinctive facial appearance. Mutations in this gene have also been associated with various cancers, including non-Hodgkin lymphoma, colorectal cancer, maligt melanoma, thyroid carcinoma, non-small cell lung carcinoma, and adenocarcinoma of lung. A pseudogene, which is located on chromosome X, has been identified for this gene.
Especificaciones
Especificaciones
| Antígeno | BRAF |
| Aplicaciones | Western Blot |
| Clasificación | Monoclonal |
| Clon | OTI1G8 |
| Conjugado | Unconjugated |
| Formulación | PBS with 8% trehalose and no preservative; pH 7.3 |
| génica | BRAF |
| N.º de referencia del gen | P15056 |
| Alias de gen | B-RAF1, B-raf, BRAF1, NS7, RAFB1 |
| Símbolos de los genes | BRAF |
| Mostrar más |
Título del producto
Al hacer clic en Enviar, acepta que Fisher Scientific se ponga en contacto con usted en relación con los comentarios que ha proporcionado en este formulario. No compartiremos su información para ningún otro fin. Toda la información de contacto proporcionada se mantendrá de acuerdo con nuestra Política de Privacidad. Política de privacidad.
¿Detecta una oportunidad de mejora?